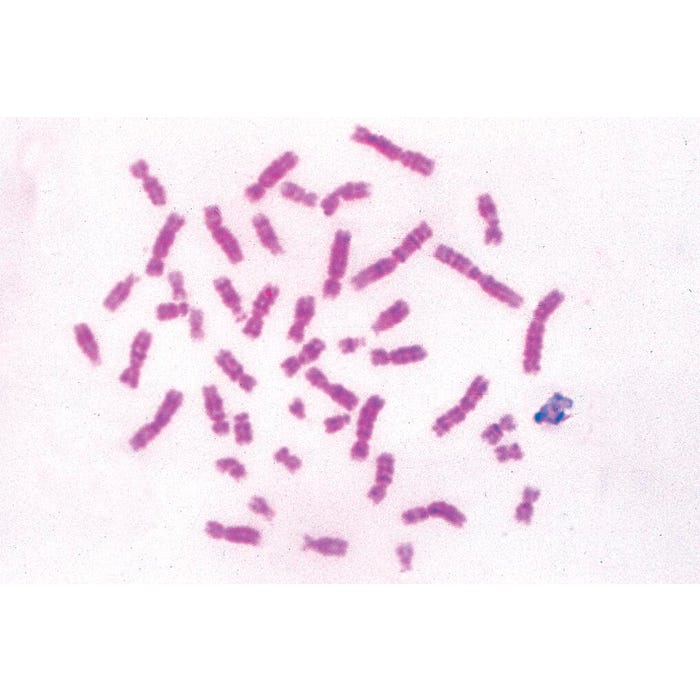
Johannes Lieder Prepared Microscope Slide, General Biology Set D, Set of 50

Shop All:
Johannes LiederJohannes Lieder Prepared Microscope Slide, General Biology Set D, Set of 50
$706.40
$1,412.79
Item #: 529440
Specifications
Maximum Age: 12 years
UPC: 885634218362
Allergens: Contains No Allergens
Grade Level: Middle-High School
Selling Unit of Measure: Set of 50
Brand Name: Johannes Lieder
Description: Series D Slides
